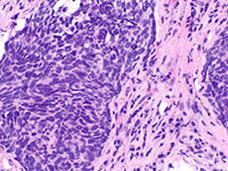

June 2017 - Temas y relatos
-
Trastuzumab emtansina mejora la supervivencia en cáncer metastático de seno con HER2 que fue tratado anteriormente
Dos estudios clínicos muestran que trastuzumab emtansina (T-DM1) mejora la supervivencia comparado con otros tratamientos convencionales para pacientes con cáncer de seno metastático con HER2 que ha avanzado después de tratamiento con otros fármacos dirigidos a HER2.
-
Regorafenib es ahora el primer fármaco aprobado por la FDA para cáncer de hígado en casi una década
FDA aprobó el inhibidor de cinasa regorafenib para algunos pacientes con carcinoma hepatocelular, la forma más común de cáncer de hígado.
-
FDA aprueba nivolumab para el cáncer de vejiga
La FDA ha aprobado nivolumab para el tratamiento de cáncer de vejiga no resecable metastático o localmente avanzado que empeoró después de tratamiento con quimioterapia a base de platino.
-
FDA otorga aprobación acelerada a brigatinib para cáncer metastático de pulmón de células no pequeñas
El 28 de abril, la FDA otorgó aprobación acelerada a la terapia dirigida brigatinib (Alunbrig™) para pacientes con cáncer metastático de pulmón de células no pequeñas (NSCLC) y alteraciones en el gen ALK cuyo cáncer ha progresado durante su terapia inicial.
-
El asesoramiento mejora la ejecución del plan de supervivencia de supervivientes de cáncer de seno de bajos ingresos
En un estudio aleatorizado, mujeres de bajos ingresos que actuaron el papel de hablar con su doctor acerca de su plan de atención de supervivencia en una sesión de asesoramiento informaron que recibieron más atención recomendada que las mujeres que no tuvieron asesoramiento.
-
FDA extiende la aprobación de pembrolizumab para tratamiento de primera línea de cáncer de pulmón de células no pequeñas
FDA aprobó el inhibidor de punto de control inmunitario pembrolizumab para usarse con quimioterapia como tratamiento de primera línea para cáncer de pulmón de células no pequeñas.
-
Vacunación contra el VPH relacionada con disminución de infecciones orales por VPH
Un estudio de más de 2600 jóvenes adultos encontró que la frecuencia de infección oral por cuatro tipos de VPH, incluyendo dos tipos que causan cáncer, fue 88 % más baja en quienes informaron haber recibido al menos una dosis de una vacuna contra el VPH que en quienes no estaban vacunados.
-
FDA aprueba midostaurin para leucemia mieloide aguda
La FDA ha aprobado midostaurin para pacientes con leucemia mieloide aguda (LMA) de diagnóstico reciente con mutaciones en el gen FLT3. La aprobación cubre también varias enfermedades raras.